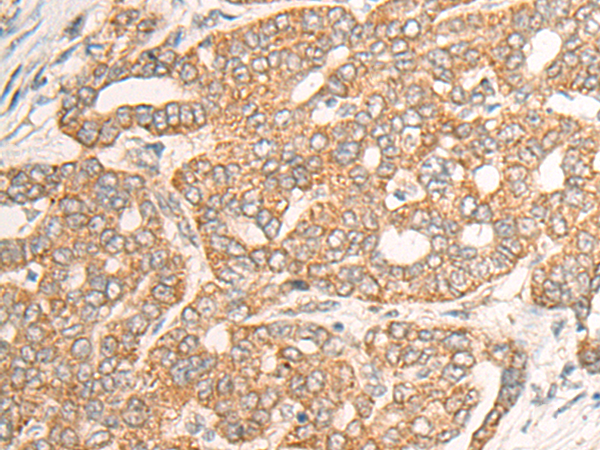

|
Background: |
The protein encoded by this gene is similar to bacterial chitinases but lacks chitinase activity. The encoded protein is secreted and is involved in cartilage biogenesis. Several transcript variants encoding different isoforms have been found for this gene. |
|
Applications: |
ELISA, IHC |
|
Name of antibody: |
CHI3L2 |
|
Immunogen: |
Fusion protein corresponding to a region derived from 191-390 amino acids of human CHI3L2 |
|
Full name: |
chitinase 3 like 2 |
|
Synonyms: |
CHIL2; YKL39; YKL-39 |
|
SwissProt: |
Q15782 |
|
ELISA Recommended dilution: |
5000-10000 |
|
IHC Positive control: |
Human liver cancer;Human tonsil |
|
IHC Recommended dilution: |
25-100 |

購物車
購物車 幫助
幫助
 021-54845833/15800441009
021-54845833/15800441009
